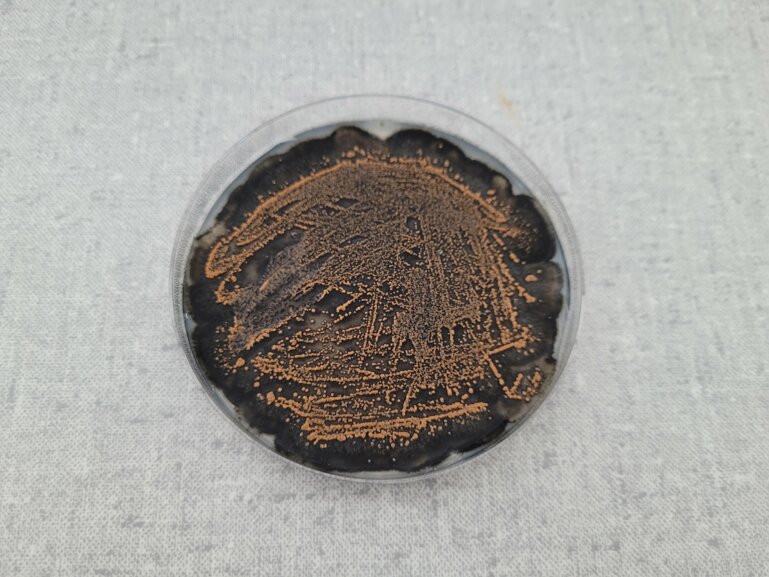
alt_text

Quer gelesen
– Züchtungsziele bei Futterpflanzen legen den Fokus auf Futterqualität, Ertrag, Resilienz und Krankheitsresistenz.
– Die genetische Vielfalt der Populationssorten sorgt für widerstands- und anpassungsfähigere Bestände.
– Besonders die Trockenheitsresistenz soll verbessert werden, aber auch neue Arten werden interessanter.
Was sind die wichtigsten Ziele bei der Züchtung von Futterpflanzen?
Michelle Nay: Um eine Sorte auf den Markt zu bringen, muss sie die Sortenprüfung bestehen. An deren Kriterien orientieren wir uns. Das sind die Futterqualität, Ertrag, Ausdauer und Krankheitsresistenz. Damit die Sorte zugelassen wird, muss sie zudem die Prüfung auf Unterscheidbarkeit und Homogenität bestehen. Eine gute Sorte per se reicht aber nicht. Aus ihr muss sich auch Saatgut produzieren lassen und das in ausreichender Menge, sonst wird es zu teuer.
Haben sich die Ziele in den letzten Jahren verändert?
Michelle Nay: Ja, der Klimawandel führt zu einer Verschiebung der Prioritäten: Ertrag und Futterqualität bleiben wichtig, während Resilienz durch Trockenstresstoleranz an Bedeutung gewinnt. Kältetoleranz und Schneeschimmelresistenz werden weniger wichtig. Dagegen ist die Resistenz gegen den Südlichen Stängelbrenner bei Rotklee für den Anbau in der Schweiz unverzichtbar geworden.
Unterscheidet sich die Züchtung von Futterpflanzen wie Gräser oder Klee von derjenigen anderer Kulturen?
Christoph Grieder: Futterpflanzen brauchen meist einen Bestäubungspartner und können sich nicht selbst befruchten wie Weizen. Gezüchtet wird eine Sorte als Population, also als Gruppe mehrerer Individuen. Dadurch ist sie genetisch diverser.
Bringt das auf dem Feld Vorteile?
Christoph Grieder: Ja, absolut. Die Genetische Vielfalt macht die Sorten resistenter und resilienter. Es wird ein paar wenige Anfällige haben, was auch gut ist, da sonst der Druck auf das Pathogen steigt, die Resistenz zu überwinden.
Welche Merkmale sind am schwierigsten zu bearbeiten?
Christoph Grieder: Eindeutig der Ertrag. Er wird von vielen Genen beeinflusst und zeigt eine starke Interaktion mit der Umwelt. Indirekt haben wir aber Einfluss, indem wir die Ausdauer der Pflanzen verbessern. Da spielt auch die Krankheitsresistenz mit rein. Allgemein sind alle Merkmale, die aufwendig zu bestimmen sind, schwieriger zu bearbeiten. Auch weil wir dann weniger Pflanzen untersuchen können. Das betrifft zum Beispiel die Futterverdaulichkeit.
Wie alt sind die Sorten im Anbau?
Christoph Grieder: Aufgrund der genetischen Diversität und des langsameren Zuchtfortschritts sind Futterpflanzen-Sorten viel langlebiger als jene anderer Kulturen. Die Raigras-Sorte Arvicola wurde von 1996 bis 2022 empfohlen. Sie stammt aber aus dem Jahr 1989. Futterpflanzen-Sorten sind tatsächlich 10 bis 20 Jahre auf dem Markt.
Wie lange dauert es, bis ein Betrieb die neue Klee- oder Grassorte auf dem Feld stehen hat?
Michelle Nay: Geht man von der ersten Kreuzung, also der neuen Kombination zweier bestehender Populationen aus, dauert es mindestens 16 Jahre. Die Produktion und Vermarktung unserer Sorten übernimmt dann unser Partner Delley Samen und Pflanzen (DSP).
Ist die gewünschte Eigenschaft, wie eine Resistenz, dann noch aktuell, wenn die Landwirtinnen und Landwirte die Sorte erhalten?
Christoph Grieder: Ein Schaderreger mag sich über die Jahre verändern, aber das tun die Pflanzen auch. Über alle Züchtungsschritte findet in der natürlichen Umgebung eine automatische Selektion statt. Pflanzen, die anfällig gegen Erreger sind, welche zu diesem Zeitpunkt auftreten, sterben ab oder werden von uns aussortiert.
Wie lange hält sich eine Resistenz?
Michelle Nay: Bei Populationssorten halten sich Resistenzen länger, aufgrund des geringeren Anpassungsdrucks auf das Pathogen. Naturwiesen in der Umgebung verstärken diesen Effekt. Da wir bisher phänotypisch, also nach dem äusseren Erscheinungsbild der Pflanze selektierten, wissen wir aber nicht, welche Resistenzen vorhanden sind und wann sie durchbrochen werden.
Welche Schwierigkeit sehen Sie derzeit für Betriebe?
Michelle Nay: Eine Trockenheit im Sommer kann häufiger werden, aber auch sehr nasse Bedingungen wie in diesem Jahr. Wichtig ist es für uns daher, die Resilienz der Pflanzen zu verbessern. Auf der Tierseite ist es eine Herausforderung, gutes Grundfutter zu produzieren, um nicht auf Kraftfutter angewiesen zu sein.
Wie reagieren Sie als Züchter darauf?
Christoph Grieder: Bei Futterpflanzen sind wir recht flexibel mit den Arten. Wir versuchen, bestehende Arten wie Raygrass trockentoleranter zu machen. Dazu testen wir die Sorten in einem Trockenstresszelt. Wir reizen die Artgrenzen so gut es geht aus, um anzubieten, was gebraucht wird. Aber auch Arten, die mit Trockenheit besser umgehen wie Luzerne oder Rohrschwingel, stehen im Fokus. Diese haben leider auch Nachteile, die wir zu beheben versuchen. Bei der Luzerne versuchen wir, die Nutzungselastizität zu verbessern. Wird sie länger nicht geschnitten, sollen die Stängel trotzdem gut verdaulich sein und nicht so hart, dass sie die Siloballen durchstechen. Beim Rohrschwingel arbeiten wir auf eine bessere Verdaulichkeit hin.
Michelle Nay: Dieser hat ursprünglich sehr harte Blätter. Es kann sogar passieren, dass man sich schneidet, wenn man mit der Hand durch den Bestand geht. Und der Saatgutertrag ist nicht zufriedenstellend.
Gibt es bereits Fortschritte?
Christoph Grieder: Zwei Generationen im Trockenstresszelt haben leichte Verbesserungen bei Raygrass gezeigt. Wie das im Feld aussieht, muss aber noch evaluiert werden. Eine tiefere Aussaat könnte in der Etablierungsphase hilfreich sein. Trockenstresstoleranz ist komplex. Es gibt bei den Pflanzen dazu extreme Strategien. Die Luzerne macht tiefere Wurzeln, um einfach weiterzuwachsen. Andere Arten reduzieren ihr Wachstum, um gut durch den Stress zu kommen, und kompensieren das später.
Widerspiegelt sich die klimatische Situation auch in der Nachfrage der Arten und welche Trends gibt es?
Michelle Nay: Rohrschwingel ist hier klar im Wachstum. Des Weiteren ist hochverdaulicher, tetraploider Wiesenschwingel im Ausland gefragt. Der Hype um Weiderotklee hat sich wiederum beruhigt. Zudem werden krautige Arten wie Chicorée oder Spitzwegerich, welche wir aber (noch) nicht züchten, zunehmend aus europäischen Ländern nachgefragt. Spitzwegerich wirkt Studien zufolge als Diuretikum im Tier, wodurch der Stickstoff mit dem Harn weniger konzentriert aufs Feld gelangt. Das hilft, Stickstoffverluste zu reduzieren.
Gibt es noch wenig genutzte Futterpflanzen, die vielversprechend sind?
Michelle Nay: Hier bleibt die Esparsette mit ihrem hohen Gehalt an kondensierten Tanninen ein ewiger Geheimtipp. Wegen des tiefen Saatgutertrags und der speziellen Standortanforderungen sehen wir sie aber noch nicht viel am Markt. Krautige Arten, speziell der Spitzwegerich, haben ein grosses Potenzial, brauchen aber noch züchterische Bearbeitung, um an die Bedingungen des Schweizer Futterbaus angepasst zu werden.
Züchten Sie auch Sorten für den biologischen Anbau?
Christoph Grieder: Wir sind die einzigen in Europa, die auch Futterpflanzen für den Bio-Bereich züchten. Diese werden speziell unter Bio-Bedingungen selektiert und gelten als Kategorie 2 nach Bio Suisse. Prinzipiell sind die Anforderungen an Sorten aber sehr ähnlich wie im konventionellen Futterbau.
Wird auf die Eignung für Mischkulturen gezüchtet?
Christoph Grieder: Das Züchten auf Mischungseignung ist sehr komplex, da sehr viele Parameter angeschaut werden müssen. Aber wir wissen, dass die Eigenleistung stark mit der Leistung in der Mischung korreliert. Zudem arbeiten wir mit Rasenwiesenrispe als Untersaat im Zuchtgarten, was die Mischungssituation etwas nachstellt.
Welche Innovationen sehen Sie in der Futterpflanzenzüchtung im nächsten Jahrzehnt?
Michelle Nay: Die Implementierung der Genomischen Selektion wird sicherlich auch bei den Futterpflanzen Fahrt aufnehmen. Wir erhoffen uns damit, die Selektion zu unterstützen und insgesamt mehr Merkmale schneller zu verbessern. Aktuell starten wir dazu ein Forschungsprojekt.
Anbautipps der Züchter
– Nicht beim Saatgut sparen, speziell bei länger andauernden Anlagen. AGFF- zertifizierte Mischungen oder entsprechende Händlermischungen nutzen, da diese ausschliesslich empfohlene Sorten enthalten. Man profitiert so von der Züchtungsarbeit und dem guten Resistenzniveau.
– Krankheiten vorbeugen. Kleekrebs befällt die Pflanzen im Herbst und überwintert dann. Hier macht es Sinn, den Bestand nicht zu üppig in den Winter gehen zu lassen und bei grösserem Befall eine Anbaupause einzulegen.